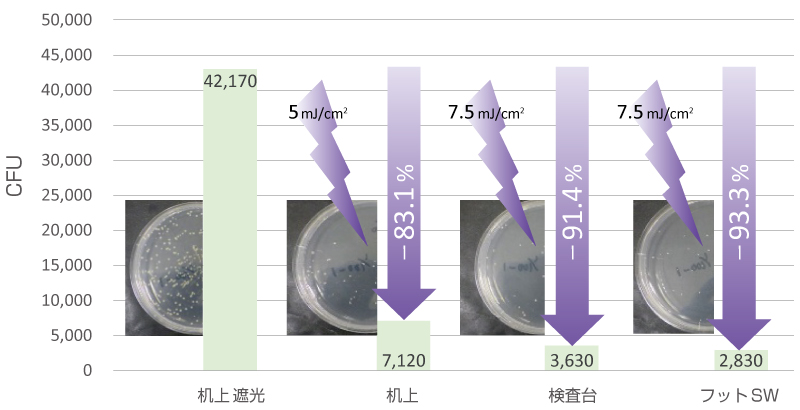

222nm紫外線を室内で照射した際の眼の長期安全性と病原微生物不活化効果について

ウシオ電機株式会社(本社:東京都、代表取締役社長 内藤 宏治、以下 ウシオ)と島根大学医学部眼科学講座の谷戸 正樹教授・杉原 一暢助教らの研究グループは、222nm Far UV-Cの眼に対する安全性に関しての観察研究および微生物不活化効果実験を実施したところ、眼に関しては急性有害事象も慢性有害事象も認められず、また微生物不活化効果実験でも黄色ブドウ球菌で90%、φX174ファージで99%の不活化が確認できましたのでお知らせいたします。なお、これらの成果は2022年9月8日付でPhotochemistry and Photobiology誌にて発表されています。
■研究及び実験内容
・222nm Far UV-Cの眼に対する安全性に関しての観察研究
ウシオの抗ウイルス・除菌用紫外線技術「Care222®」搭載ユニットの設置前後で、診察室を日常的に使用する医療従事者の紫外線による眼の障害の有無を1年間にわたり確認。その結果、急性有害事象も慢性有害事象も認められませんでした。

図1 眼科外来診察室

図2 代表症例

表1 評価結果
・微生物不活化効果実験
観察研究を実施した診察室で、微生物不活化効果実験を実施。その結果、黄色ブドウ球菌で90%、φX174ファージで99%の不活化が確認されました。

図3 222nm Far UV-C照射による微生物の不活化効果の確認
図4. 222nm Far UV-C照射による微生物不活化効果の確認(黄色ブドウ球菌培養 結果)

図5. 222nm Far UV-C照射による微生物不活化効果の確認(φX174ファージ培養 結果)
これらの結果、222nmの国際的な安全性基準※1(暴露許容限界値、以下 TLV)であるACGIHが2022年以前に推奨していた22mJ/cm2を超えない照射環境下において、眼と顔面皮膚への影響がないことが人で示され、かつ有効な微生物の不活化が期待できることが示されました。
ウシオは222nmの皮膚や目の急性、慢性障害などに対する安全性の研究・確認を国内外の研究機関と進めており、今後も眼科領域分野においては、引き続き島根大学とさらなる詳細な研究を進めてまいります。また、医療機関や社会福祉施設、飛行機、旅客船などでのウイルス対策のほか、今後は医療機器の展開を視野に商品化を目指し、「光」による安心・安全な社会の実現に貢献していきます。
※1 ACGIH(American Conference of Governmental Industrial Hygienists)は、紫外放射の急性障害に関する暴露許容限界値(TLV)を勧告しており、このACGIHのTLVを元に、各地域における国際規格(IEC, UL, JIS)にて222nmを含む紫外線の許容値がそれぞれ規定されています。
参考資料
■Photochemistry and Photobiology誌での発表内容について
・論文情報
タイトル: “One-year ocular safety observation of workers and estimations of microorganism inactivation efficacy in the room irradiated with 222-nm far ultraviolet-C lamps.”
著者: 杉原 一暢、海津 幸子、佐々木 正裕、市岡 昇、高柳 佑士、清水 啓史、佐野 一矢、原 克典、谷戸 正樹
掲載誌: Photochemistry and Photobiology. 2022、印刷中
【ポイント】
波長222nmをピークに持つエキシマランプに特殊な光学フィルターを組み合わせることで、ヒトに悪影響を及ぼす230nm以上の波長をカットした、ウシオの抗ウイルス・除菌用紫外線技術「Care222®」を搭載したユニットを外来診察室に設置。照射量はその部屋で1日8時間過ごしても222nm のTLV(ACGIHが2022年以前に推奨していた22mJ/cm2)を超えないよう設定。
・この診察室で診察する6人の医師(1週間あたりの平均診察室滞在時間:6.7時間)を観察。1年間の観察で、急性有害事象(角膜びらん、結膜充血、眼瞼皮膚紅斑など)、慢性有害事象(翼状片、白内障、眼瞼腫瘍など)を認めなかった。また、視力、屈折度数、角膜内皮細胞密度も変化なし。
・同診察室の机、検査台、床に留置した細菌・ファージへ222nm Far UV-Cを照射(5〜7.5mJ/cm2)。φX174ファージの >99%不活化および黄色ブドウ球菌の>90%不活化が見られた。
・222nm Far UV-C による菌・ウイルスへの不活化効果がある環境下でも、人の眼や皮膚への影響は極めて低いことが示唆された。
【詳細】
従来から紫外線殺菌に広く用いられる254nm UV-Cは細菌やウイルスに対して効果的ですが、人間の皮膚や眼には有害で少しの線量でも紅斑や角膜炎を起こす恐れがあります。一方、222nm Far UV-Cは、動物実験で眼や皮膚への安全性が確認されているため、人にとっても安全な条件下で細菌やウイルスを不活化することが可能な室内紫外線照射への応用が期待されます。しかし、実際に人での安全性を長期間確認した報告はありませんでした。そこで、222nm Far UV-C 室内照射を行っている環境で、眼の安全性の長期評価と菌・ウイルスへの効果を確認しました。
・眼の安全性に関する観察研究
2台の「Care222®」搭載ユニットを、眼科外来診察室の天井付近に医師と患者の間にある検査テーブルが照射されるよう設置し、照射量はその部屋で1日8時間過ごしてもTLV(ACGIHが2022年以前に推奨していた22mJ/cm2)を超えないように設定しました。診察室で診察を行う6人の眼科医師を対象に、照射開始前、照射開始翌日、および1、 3、 6、 12か月後に眼の検査を実施。両眼の最良矯正視力、等価球面屈折度数、細隙灯検査所見(角膜びらんスコア、結膜充血スコア、翼状片の有無、白内障の有無、眼瞼皮膚の変化)、角膜内皮細胞密度、自覚症状、その他の有害事象を記録しました。なお、1年間の医師の平均診察室滞在時間は1週間あたり6.7時間でした。その結果、前向き観察で、急性有害事象(角膜びらん、結膜充血、眼瞼皮膚紅斑など)、慢性有害事象(翼状片、白内障、眼瞼腫瘍など)ともに認められませんでした。視力、屈折異常、角膜内皮細胞密度に変化はありませんでした。
・室内紫外線照射の微生物不活化実験
同じ診察室で微生物の不活化実験を行いました。実験では、黄色ブドウ球菌(NBRC 12732)、φX174ファージ(NBRC 103405)、φX174ファージ宿主用大腸菌(NBRC 13998)を用いました。生理食塩水に懸濁した104コロニー形成単位(CFU)の黄色ブドウ球菌または105プラーク形成単位(PFU)のφX174ファージを入れたプラスチック皿を、診察室の机の上、検査テーブル、床に置いて、天井付近の「Care222®」搭載ユニットから照射線量は 5-7.5mJ/cm2とし222nm Far UV-Cを照射。照射後に試料を回収・培養し、コロニーまたはプラークの数をカウントしました。黄色ブドウ球菌のコロニー数は、コントロール(42,170 CFU)と比較して、222nm Far UV-C照射サンプル(2,830-7,120 CFU)で有意(p<0.0001)に低く、不活化率は 83.1-93.3 %でした。φX174ファージのプラーク数は、コントロール(147,000 PFU)と比較して、222nm Far UV-C照射サンプル(40-950 PFU)で有意(p<0.0001)に低く、不活化率は99.4-99.97 %でした。
上記の結果から、実際の臨床環境でも222nm Far UV-C照射は人の健康への影響は極めて低い一方で、高い微生物の不活化効果を有する事が示唆されました。今後、さらなる検証や議論が望まれます。
***
国立大学法人島根大学
島根大学は6学部4研究科を有す総合大学として、大学の機能強化を図りながら、地域や国際社会で活躍する人材の育成、知の拠点としての地方創生という大きな役割を果たし、地域に活き世界で輝く大学として発展を続けています。 2018年には「次世代たたら協創センター」を開設し、金属材料分野において島根県及び関連企業との連携強化のもと、地域産業の振興を担う高度人材の育成と最高水準の研究開発拠点の形成を目指しています。
